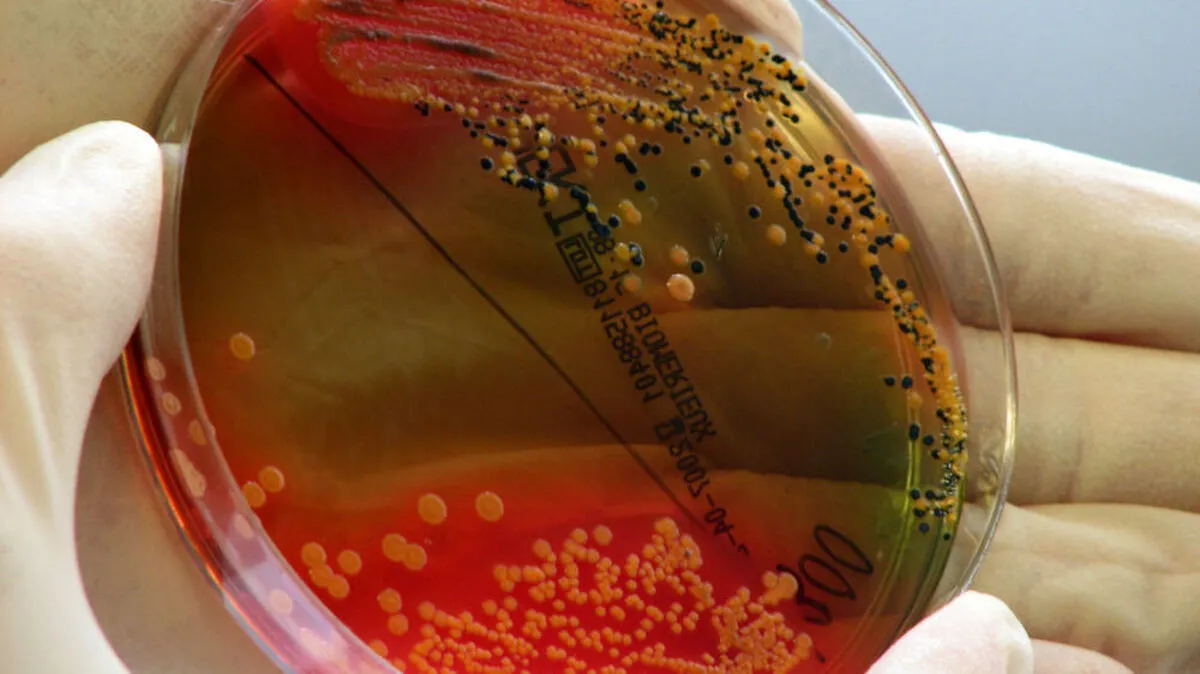

Salmonellen sind in der EU die häufigste Ursache für Krankheitsausbrüche durch Lebensmittelkeime. Fast jeder dritte solche Ausbruch sei 2018 von Salmonellen verursacht worden, teilte die EU-Behörde für Lebensmittelsicherheit EFSA am Donnerstag mit. Demnach gab es in der EU knapp 5.150 Ausbrüche, die mehr als 48.000 Menschen betrafen.
EU-Bericht
Salmonellen häufigste Ursache für Krankheiten durch Lebensmittelkeime
Ein neuer EU-Bericht zu Zoonosen liegt vor: Die häufigste Infektionsquelle sind Bakterien der Gruppe Campylobacter.
© (c) AP (MARTIN ANGELSTEIN)